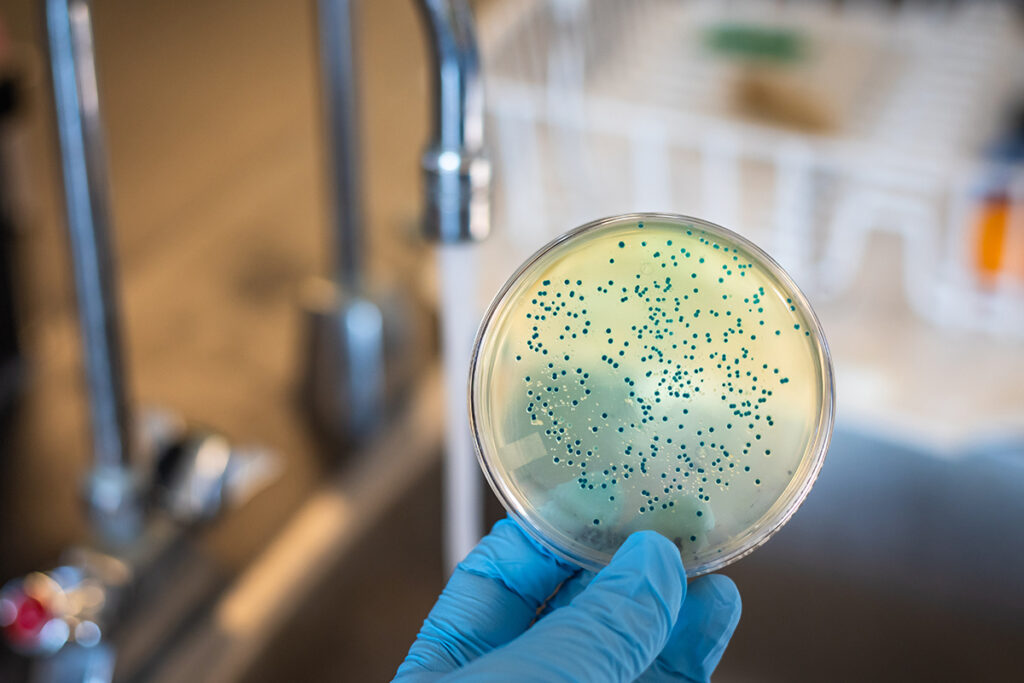
Legionella risk assessment testing process

Mobile Legionella Risk Assessment Testing in London
Comprehensive Testing Services at Your Location
Need reliable Legionella risk assessment testing? Our qualified team provides thorough assessments directly at your property in London. From £150, we ensure your premises meet safety and compliance standards, protecting your health and the environment.

Book Your Assessment Now
Legionella Risk Assessment Pricing in London
Basic Assessment
- Initial risk assessment
- Water sampling and analysis
- Basic compliance report
- Follow-up consultation
Comprehensive Assessment
- In-depth risk assessment
- Multiple water samples and analysis
- Detailed compliance report
- Recommendations for mitigation
Full Compliance Package
- Full risk assessment and testing
- Comprehensive report with action plan
- Ongoing monitoring and support
- Priority scheduling for follow-ups
Professional Legionella Risk Assessment Specialists in London
At Legionella Risk Assessment Testing London, we specialise in providing thorough Legionella risk assessments directly at your location. Our team of certified professionals ensures compliance with health and safety regulations, protecting your property and its occupants.
Whether you manage a residential building, commercial property, or hospitality venue, our mobile assessment services are designed for your convenience. We follow strict protocols and use advanced testing methods to deliver accurate results and actionable recommendations.

What Is Legionella Risk Assessment Testing?
Legionella risk assessment testing involves evaluating water systems to identify potential risks for Legionella bacteria growth. This testing is crucial for ensuring the safety of water supplies in residential and commercial properties.
Our mobile Legionella testing service in London allows you to receive thorough assessments without the need to travel. We bring our expertise to your location, ensuring compliance with health regulations and protecting the health of your occupants.
- ✓ On-site assessments conducted by certified professionals
- ✓ Comprehensive water sampling and analysis
- ✓ Detailed reporting and recommendations
- ✓ Compliance with health and safety regulations
Why Choose Our Legionella Risk Assessment Service in London?
Certified Professionals
Our assessments are conducted by qualified professionals with extensive experience in Legionella risk management and compliance.
Mobile Service
We come directly to your location in London, saving you time and ensuring a convenient assessment process.
Same-Day Assessments
Book your assessment and have a professional arrive within hours. Perfect for urgent compliance needs.
Transparent Pricing
Flat rates starting from £150 – no hidden costs. All travel, consultation, and reporting are included in your price.
Comprehensive Reporting
Receive detailed reports with actionable recommendations to mitigate risks and ensure compliance.
Local London Coverage
Our team covers all areas of London, providing fast access to all major postcodes for assessments.
Types of Legionella Testing Available in London

Basic Assessment
Initial risk assessment and water sampling to identify potential Legionella risks. Ideal for small properties.
- • Quick analysis for immediate results
- • Basic compliance report
- • Follow-up consultation included

Comprehensive Assessment
In-depth analysis with multiple water samples and detailed reporting. Suitable for larger properties and businesses.
- • Thorough risk evaluation
- • Detailed compliance report
- • Recommendations for risk mitigation

Full Compliance Package
Complete testing and ongoing monitoring to ensure full compliance with health regulations. Best for high-risk environments.
- • Comprehensive assessment and testing
- • Ongoing support and monitoring
- • Priority scheduling for follow-up assessments
Why Legionella Risk Assessment Testing Is Important
Legionella bacteria can pose serious health risks, leading to illnesses such as Legionnaires' disease. Regular Legionella risk assessment testing is essential for identifying potential hazards in water systems and ensuring compliance with health regulations.
Our mobile testing service provides peace of mind, ensuring that your property is safe for occupants. Each assessment is tailored to your specific needs, helping you mitigate risks effectively.
Prevent illness by identifying and addressing Legionella risks in your water systems.
Ensure your property meets health and safety regulations to avoid penalties and liabilities.
Regular assessments provide assurance that your water systems are safe and compliant.

What’s Involved in Getting a Legionella Risk Assessment in London?
Consultation & Booking
We start with a brief consultation to understand your needs and schedule your assessment at a convenient time.
Assessor Arrival & Preparation
A qualified assessor arrives at your location with all necessary equipment to conduct the testing safely and efficiently.
Thorough Assessment
The assessment involves water sampling, analysis, and evaluation of your water systems to identify potential risks.
Post-Assessment Report
Once the assessment is complete, you will receive a detailed report outlining findings and recommendations for compliance.
How Long Does a Legionella Risk Assessment Take in London?
Consultation & Booking
Our consultation is quick and efficient — tell us your needs, and we’ll arrange a visit at your convenience.
Assessment Time
The assessment typically takes between 30 to 60 minutes, depending on the size and complexity of the water systems.
Total Visit Duration
From assessor arrival to completion, the full appointment usually lasts around one hour — no travel needed, just convenience.
Typical Appointment Timeline
When Is Legionella Risk Assessment Testing Recommended in London?
🏠 Property Management
Regular assessments are essential for property managers to ensure compliance and protect residents from health risks.
🏨 Hospitality Venues
Hotels and restaurants must conduct assessments to maintain safety standards and protect guests from Legionella outbreaks.
🏢 Commercial Buildings
Offices and commercial properties require regular testing to ensure safe water systems and compliance with health regulations.
🏥 Healthcare Facilities
Healthcare providers must prioritize Legionella risk assessments to protect vulnerable patients and comply with regulations.
How Legionella Risk Assessment Sessions Are Conducted in London
Every Legionella risk assessment is conducted by a qualified professional who adheres to strict hygiene and safety protocols. We bring all necessary equipment, including sampling kits and testing materials, directly to your location.
The assessor verifies your property details, conducts the assessment, and prepares a comprehensive report. Most clients receive their results within a few days, ensuring timely action can be taken if needed.
Pre-Assessment Safety Steps
- ✓ Consultation and property evaluation before testing
- ✓ Verification of water systems and risk factors
- ✓ Use of sterile sampling equipment and protocols
- ✓ Detailed reporting and follow-up recommendations

Benefits of Legionella Risk Assessment Testing in London
Immediate Risk Identification
Identify potential Legionella risks quickly, allowing for timely interventions and compliance with health regulations.
Enhanced Safety
Protect your property and its occupants from health risks associated with Legionella bacteria.
Comprehensive Reporting
Receive detailed reports with actionable recommendations to mitigate risks and ensure compliance.
Peace of Mind
Regular assessments provide assurance that your water systems are safe and compliant with health regulations.
Regulatory Compliance
Ensure your property meets all necessary health and safety regulations to avoid penalties and liabilities.
Expert Guidance
Our qualified assessors provide expert advice and support to help you maintain safe water systems.
Who Needs Legionella Risk Assessment Testing in London?
🏢 Property Managers
Ensure compliance and protect residents from health risks associated with Legionella bacteria.
🏨 Hotel Owners
Maintain safety standards and protect guests from Legionella outbreaks in your water systems.
🏥 Healthcare Providers
Prioritize Legionella risk assessments to protect vulnerable patients and comply with regulations.
🏢 Business Owners
Ensure the safety of your employees and clients by conducting regular Legionella risk assessments.
🏠 Homeowners
Protect your family by ensuring your home’s water systems are safe from Legionella bacteria.
🏗️ Construction Companies
Ensure compliance with health regulations on new builds and renovations involving water systems.
Our Legionella Risk Assessment Location in London
Service Area: Greater London
Address: 26 Eaton Pl, London SW1X 8AF
Phone: 07472092719
Service Radius: 25 miles around Central London
Client Reviews for Legionella Risk Assessment Testing London
"Fantastic service! The assessor arrived on time and conducted a thorough assessment. The report was clear and detailed. Highly recommend!"
"We needed a quick assessment for our hotel, and the team was very responsive. The process was smooth and professional. Thank you!"
"The assessment was comprehensive and the follow-up support was excellent. We now feel confident that our water systems are safe."
Key London Areas We Serve
Central London
We provide Legionella assessments in areas such as Soho, Covent Garden, and Fitzrovia. Fast response times for property managers and business owners.
West London
Comprehensive testing services for clients in Kensington, Chelsea, and Notting Hill — ensuring safety and compliance for residential and commercial properties.
City & East London
Expert Legionella assessments for busy professionals in Shoreditch, Canary Wharf, and the City. Ideal for maintaining safe water systems.
Frequently Asked Questions – Legionella Risk Assessment Testing London
Legionella risk assessment testing involves evaluating water systems to identify potential risks for Legionella bacteria growth and ensuring compliance with health regulations.
Legionella risk assessment testing prices in London start from £150 per assessment. The cost depends on the type of assessment and includes all necessary testing and reporting.
Yes. Our assessments are conducted by qualified professionals using safe and sterile methods. Each client receives a thorough consultation to ensure safety and suitability.
The assessment typically takes between 30 to 60 minutes, with the entire visit lasting around one hour from arrival to completion.
Clients receive a detailed report outlining findings, recommendations for compliance, and any necessary actions to mitigate risks associated with Legionella.
It is recommended to conduct Legionella risk assessments at least annually, or more frequently depending on the type of property and water system.
Yes! You can customize your assessment package by adding additional services such as ongoing monitoring or follow-up assessments. Discuss your needs with our assessor.
Areas We Serve Near London
Baker Street
Mobile Legionella risk assessment testing available in Baker Street — ensuring safety and compliance at your property.
Bond Street
Comprehensive testing services in Bond Street for residential and commercial properties seeking Legionella assessments.
Oxford Circus
On-demand Legionella risk assessments in Oxford Circus — perfect for busy property managers and business owners.
Piccadilly Circus
Expert Legionella testing services across Piccadilly Circus hotels and apartments, ensuring compliance and safety.
Leicester Square
Fast Legionella assessments for visitors and property managers in Leicester Square — ensuring safe water systems.
Covent Garden
Discreet at-home and commercial Legionella risk assessments in Covent Garden for safety and compliance.
Don’t see your area listed? We cover all of London and nearby regions within 25 miles.
Call to Check Coverage